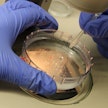
Sähköisen lähete ei syrjäytä pdf-pohjaista lähetettä, Ruokavirasto kertoo.

Ruokavirasto: Viimeiset vuoden 2023 viljelijätuet maksuun 20.6.2024 alkaen
Loppuerä viljelijätukia valmiina maksuun. Yli 93 miljoonan euron potin maksupäivä vahvistui.
Talviaikainen kasvipeite -toimenpiteestä maksettava ekojärjestelmätuki maksetaan kokonaisuudessaan kesäkuussa. Kuva: Jarno MelaRuokavirasto aloittaa vuoden 2023 perustulotuen, uudelleenjakotulotuen, nuorten viljelijöiden tulotuen, tärkkelyskasvipalkkion, erikoiskasvipalkkion ja ekojärjestelmätuen loppumaksujen maksamisen maatiloille 20.6.2024.
Loppumaksujen osuus on noin viisi prosenttia tuen kokonaismäärästä.
Poikkeuksena on talviaikainen kasvipeite -toimenpiteestä maksettava ekojärjestelmätuki, joka tulee 20.6. alkaen maksuun kokonaisuudessaan.
Yhteensä nyt maksettavat tuet ovat suuruudeltaan noin 93 260 000 euroa.
Viljelijät saavat maksuja tileilleen, kunhan kunnat hyväksyvät maksuaineistoja, Ruokavirasto tarkentaa.
EU:n maatalouspolitiikan uudistus toi muutoksia viljelijätukien maksuaikatauluun. Säädösten perussääntö on, että tukia voidaan maksaa hakuvuoden joulukuusta alkaen seuraavan vuoden kesäkuun loppuun asti.
Perustulotuen, uudelleenjakotulotuen, nuorten viljelijöiden tulotuen, tärkkelyskasvipalkkion, erikoiskasvipalkkion ja ekojärjestelmätuen loppuosat ovat viimeisiä vuodelta 2023 maksettavia viljelijätukia.
Artikkelin aiheet- Osaston luetuimmat